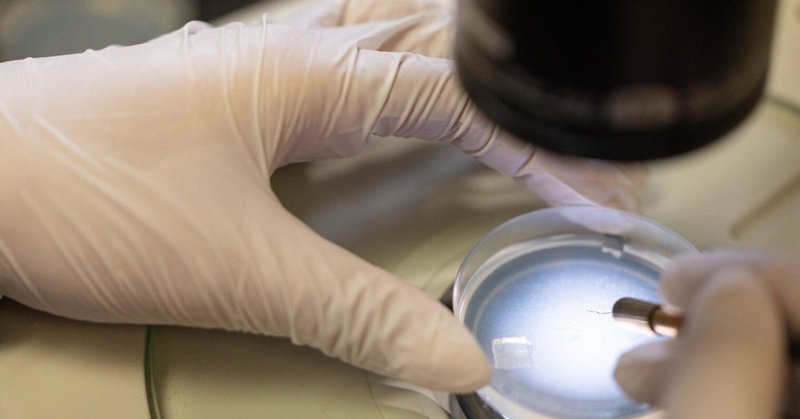
Tweet card summary image

USC Leonard Davis School of Gerontology
@USCLeonardDavis
Followers
4K
Following
2K
Media
756
Statuses
5K
The USC Leonard Davis School of Gerontology is the leading institution for aging research and education.
Los Angeles, CA
Joined March 2009
The newest issue of Vitality Magazine is out! In this issue, we're celebrating 50 years of achievement and shaping the future of #aging for individuals, families, and societies everywhere. #Gerontology #50Years #USCLDSG
https://t.co/489fXmLDiA
gero.usc.edu
Celebrating 50 years of achievement and shaping the future of aging for individuals, families, and societies everywhere.
0
0
1
The USC Leonard Davis School of Gerontology is proud to be highlighted in this feature on how @USC and @UCLA collaborate beyond the field to create meaningful impact for our communities. Together, researchers from both institutions are working to advance healthy aging, strengthen
today.usc.edu
Trojan and Bruin faculty and students often work together to tackle societal challenges and spark discovery in medicine, technology and more. (They even play games together!)
0
4
9
Rigo Saborio MSG ‘94 has had a long, successful career as a leader in aging policy and advocacy. As President and CEO of @ArchstoneFdn, his vision is to amplify older adults’ voices so they can advocate for their needs, access quality health care and social services, and
gero.usc.edu
Over a long career, Rigo Saborio MSG ’94 has helped improve aging services for older adults. He is a leader in aging policy, advocacy and philanthropy.
0
0
0
We're having a great time at the Gerontological Society of America's (GSA @geronsociety) #GSA2025. Find the schedule of USC Leonard Davis School presenters at https://t.co/FV8saHdWxb, and make sure to stop by exhibitor booth #403 to connect with us at the event! ✌️
0
0
2
🎉 Congratulations to Dean Pinchas Cohen on receiving the Robert W. Kleemeier Award at #GSA2025 Watch the award tribute presented by University Professor & AARP Chair in Gerontology Eileen Crimmins below: https://t.co/6vUaFHn3JA
@geronsociety
0
1
3
Caregiving stories can change lives. Don’t miss The Power of Storytelling webinar on Nov 18 for National Family Caregivers Month. 10–11:15 am PT / 1–2:15 pm ET. Register now. @USCLeonardDavis @USCAnnenberg @KECKSchool_USC
0
3
4
Even when blood pressure is well controlled, older adults whose blood pressure fluctuates widely from one heartbeat to the next may be at greater risk for brain shrinkage and nerve cell injury, according to a new study. https://t.co/IXVK9iqZX8
gero.usc.edu
USC-led study finds that heartbeat-to-heartbeat blood pressure instability correlates with loss of brain tissue.
0
0
0
A new USC study led by Assistant Professor Lauren Brown will harness cutting-edge molecular tools to better predict dementia risk in older adults from historically underrepresented communities, thanks to support from the 2025 Hanson-Thorell Family Research Award.
gero.usc.edu
Assistant Professor Lauren Brown aims to improve the accuracy of epigenetic clocks to better predict dementia risk in Black and Latine populations.
0
2
4
.@NIHAging has awarded a $6.5 million, five-year grant to @CedarsSinai, @USC and @UCLA to create the Los Angeles Claude D. Pepper Older Americans Independence Center. This new collaboration will take on one of today’s most pressing challenges: helping people live not just longer,
gero.usc.edu
The National Institute on Aging has awarded a $6.5 million, five-year grant to Cedars-Sinai, USC and UCLA to create the Los Angeles Claude D. Pepper Older Americans Independence Center.
0
4
8
.@AnnenbergMedia reports that USC professor Duke Han is co-leading a $39 million NIH-funded initiative to develop an accessible, open-source digital platform for detecting Alzheimer’s-related brain changes earlier. https://t.co/l8E12PU8No
uscannenbergmedia.com
Professor of Psychology and Family Medicine, Duke Han, joined an initiative to create a digital platform that enhances Alzheimer’s assessment and prevention.
0
2
2
Lesley Holmes is a gerontologist, chef and mom. After a winding career path, she opened Indalo Homes — a board and care home in Santa Monica, California. Board and care homes are licensed residential assisted living facilities, typically with six beds. “I often feel like they’re
gero.usc.edu
Lesley Holmes used her gerontology training, chef skills and a love of multi-generational collaboration to create a vibrant board and care home.
0
0
0
A degree can add decades to your life. @USCLeonardDavis research shows education slows biological aging and helps people live longer. 🔗 https://t.co/izOIpy1UWD
0
2
8
Cellular senescence gene expression composite scores capture meaningful variation in aging-related health and complement existing epigenetic #aging #biomarkers. By Qiao Wu, Eileen M. Crimmins, et al. from @USCLeonardDavis
https://t.co/MIn0e2ZklW
1
1
4
🔬 New this fall: USC’s MS in Aging Biology (MSAB) pairs advanced coursework with hands-on lab training to prepare future leaders in health, #longevity & #biotech. https://t.co/pGQP6o05kM
#AgingScience #STEM
gero.usc.edu
The USC Master of Science in Aging Biology program equips students to explore the cellular, molecular and genetic mechanisms underlying aging.
0
1
2
.@Upworthy highlights research involving Andrei Irimia, who coauthored a study showing that the Tsimané and Mosetén peoples may benefit from subsistence-lifestyle patterns including high physical activity, minimal processed food & a balanced diet. https://t.co/cenHXMVQhX
scoop.upworthy.com
Researchers are amazed by a Bolivian tribe with almost no dementia—turns out, their diet might be the key to staying healthy for life.
0
0
1
.@WashingtonPost quoted Pinchas Cohen responding to remarks about living to 150 & noting that, despite gains in average life expectancy, maximum lifespan hasn’t climbed. “The maximum life expectancy has not risen,” Cohen said. “There is no evidence anyone is going to exceed 120.”
washingtonpost.com
The leaders of China and Russia discussed medical advances and whether a human might reach the age of 150. Two experts in the longevity field have a “$1 billion” wager riding on the question.
0
0
2
President Kim, Provost, deans, former Governor Schwarzenegger + democracy — hear why your voice matters. #DemocracyDay
@GovArnoldUSC
2
15
28
.@nypost highlights a USC Leonard Davis School study showing that older adults in regions with frequent #HeatWaves experience accelerated biological aging. https://t.co/aeMTPfCS8R
nypost.com
The research, published this week in the journal Nature Climate Change, compared the effect to the impact of a tobacco or alcohol habit.
0
0
0
Offering a modest gift card significantly increased enrollment of low-income individuals in a patient registry designed to accelerate Alzheimer’s disease clinical trials, a new USC study finds. https://t.co/dvLE9DU4h4
0
1
4